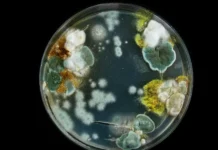
Trichophyton indotineae и мнение Елены Мескиной и Николая Крючкова о новых вызовах медицины i mnenie eleny meskinoj i nikolaya kryuchkova o novyh vyzovah medicziny-urbandigest-ru-0

С приходом осени традиционно ожидается рост заболеваемости коронавирусом и другими ОРВИ. Врач-инфекционист Елена Мескина поделилась ожиданиями относительно вероятности новой волны COVID-19 в столице и появления обновленных вариантов возбудителя.
Специалист уверена, что этой осенью непременно появятся модифицированные штаммы вируса.
— Вирусы постоянно эволюционируют, поэтому новые формы коронавируса неизбежны. Однако каждое последующее заражение обычно переносится легче первоначальных волн. Серьезные последствия для здоровья маловероятны, — прокомментировала Мескина.
Хотя предсказать скорость распространения обновленных штаммов сложно, инфекционист предполагает умеренный рост случаев в Москве.
— Даже летом циркуляция вируса сохраняется: многие переносят инфекцию бессимптомно. К осени у них формируется защита, снижающая восприимчивость к новым формам, поэтому масштабного всплеска не ожидается, — пояснила эксперт.
Сезонный подъем ОРВИ Мескина связывает с естественной уязвимостью иммунитета, подчеркивая важность своевременной вакцинации.
— Вирусы постепенно становятся заразнее, но менее опасными, а иммунный ответ ослабевает со временем. При появлении нового штамма риск повторного заражения существует. Ключевую роль играет количество полученных прививок. У ревакцинировавшихся и переболевших COVID-19 многократно риски минимальны, — отметила инфекционист.
Обновленные формы коронавируса, зафиксированные в мае в Азии и США, и меры профилактики прокомментировал аллерголог-иммунолог Владимир Болибок.
Источник: vm.ru